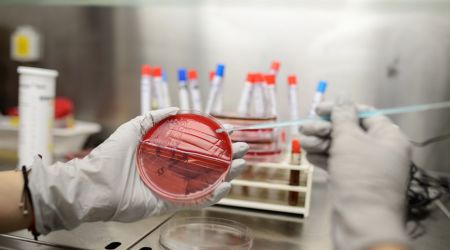
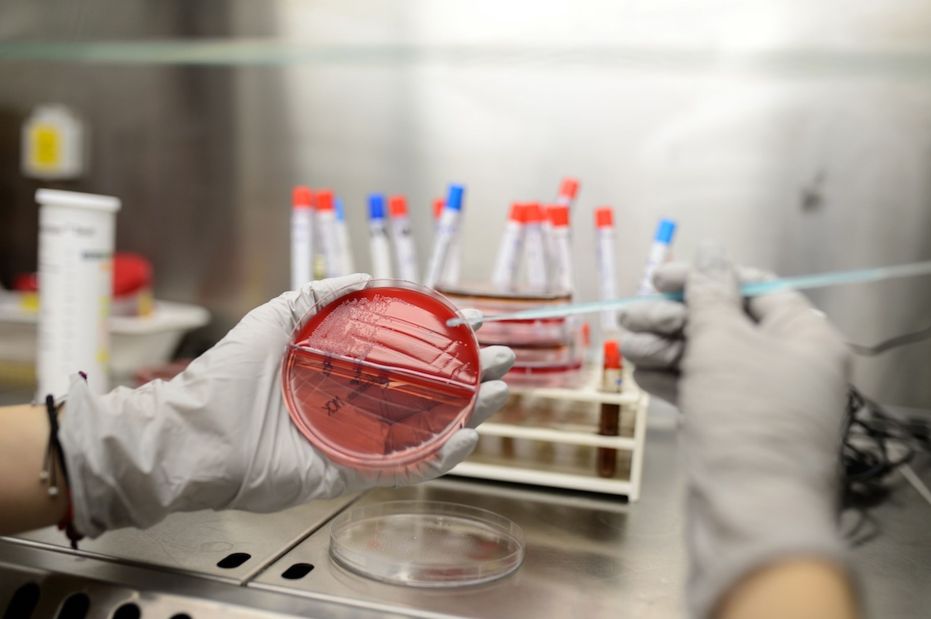

Leading Hospital in Cyprus
A Superb Hospital with a focus on Patient Care
It is an ultra-modern facility whose main purpose is the provision of the best possible and most complete medical care a patient can benefit from.
It is the only hospital in Cyprus with over 120 physicians of all specialties with a high level of scientific competence.
In addition, the excellent nursing care and the state-of-the-art technological and modern equipment make the hospital a pioneer in the field of healthcare in Cyprus.
The first and foremost priority and mission of the hospital is to create and offer high-grade health services, in order to meet the needs and expectations of anyone who might choose to benefit from them.

The Leading Multidisciplinary Hospital in Cyprus
This hospital was founded in 1991 in Nicosia and became the first private hospital in Cyprus.
With over 90 beds, the hospital’s primary goal has been to offer high quality healthcare services to Cypriot and international patients.
The hospital focuses on providing the best treatment whilst ensuring patients receive a caring approach to medical treatment.
They have a unique Neurosurgery - Orthopedic ward with specialized nursing staff, ready to attend to patients in need at any time.
To ensure that all patients are fully taken care of, no matter how serious their condition is, there is an Intensive Care Unit and a High Dependent Unit.
The hospital performs one-day surgery unit with all the latest minimally invasive operation techniques in all medical specialities.
Doctors are all board-certified and trained in competitive teaching hospitals in countries like the United Kingdom, United States, Greece, Germany, etc. 90% of the nursing staff is highly qualified with a bachelor’s degree in nursing and 30% have higher credentials such as a master’s degree.
Ensuring patients are comfortable whilst having their treatment is a priority at this hospital.
The hospital is also ISO certified and has excellent professional practice standards in relation to hospital operation.
Specialities:
- Orthopaedic Surgery
- Urology
- Ophthalmology
- Vascular Surgery
- Haematology
- Radiology
- Gastroenterology
- General Surgery
- Gynaecology
- Dermatology
- Endocrinology
- Cardiology
- Thoracic Surgery
- Cardiovascular Surgery
- Neurology
- Neurosurgery
- Plastic Surgery
- Oral & Maxillofacial Surgery
- Otorhinolaryngology (ENT)
Contact the Hospital directly through Telephone, Email or WhatsApp or visit the website for more details.